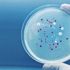
Umut veren araştırma: Yeni bir antibiyotik familyası keşfedildi

MORE IN TEHNOLOJI»

Son kurban Gizem!
13 Şubat 2018 08:54
Finike'de kaza: 1 ölü, 3 yaralı
13 Şubat 2018 17:55
Cezaevi firarisi polisin dikkati sayesinde yakalandı
13 Şubat 2018 17:55
Ziraat Bankası'nın Çin'den aldığı kredinin 400 milyon doları hes…
13 Şubat 2018 08:54
Millî savaş uçağı için mühendis seferberliği
13 Şubat 2018 02:49
İstanbul'da uyuşturucu operasyonu
13 Şubat 2018 06:49
Ormanda bıçaklı kavga: 1 ölü, 2 yaralı
13 Şubat 2018 13:01
Ayakkabı atölyesinde yangın
13 Şubat 2018 19:54 resimsizCanlı: Juventus-Tottenham maçı izle | TRT 1 canlı yayın
13 Şubat 2018 19:54 resimsizAli Şen: Ali Koç, Fenerbahçe için büyük şans
13 Şubat 2018 19:54 resimsizRemzi Kartal ve Zübeyir Aydar'a yargı yolu açıldı
13 Şubat 2018 19:54
Maçka Parkı'nda protesto eylemi
13 Şubat 2018 19:54 resimsizABD'ye kask şoku... Yasaklandı
13 Şubat 2018 19:54
Kızaktan düşen ABD'li sporcu gözyaşları içinde hastaneye kaldırı…
13 Şubat 2018 19:54
Evine gelip para isteyen 2 kişiyi av tüfeğiyle öldüren zanlı tut…
13 Şubat 2018 19:54
Pendik'te inşaatın asansör boşluğunda iki ceset bulundu (2)
13 Şubat 2018 19:54
'Dirsek atma' cinayetine 11 yıl 8 ay hapis
13 Şubat 2018 19:54
Mehmetçiğe destek
13 Şubat 2018 18:55 resimsizKadınlardan gizlice omurilik sıvısı alan çete üyeleri yakalandı
13 Şubat 2018 18:55
Trabzon tanıtım TIR'ı İslahiye'de
13 Şubat 2018 18:55
Develide doğalgaz abone sayısı 8250'ye ulaştı
13 Şubat 2018 08:54
'Zeytin Dalı Harekatı'nda 25'inci gün; 1439 terörist öldürüldü (…
13 Şubat 2018 13:01
Afrin şehidini icraya veren avukatın bürosuna saldırı
13 Şubat 2018 17:55
Aytemiz Alanyaspor Başkanı Çavuşoğlu: "Bu yıl canımız çok yandı"
13 Şubat 2018 17:55 resimsizPakistan'a 600 milyon TL yatırım
13 Şubat 2018 17:55 resimsizKilis'te boş araziye 2 havan mermisi atıldı
13 Şubat 2018 17:55 resimsizCaner Erkin ile Asena Atalay’ın velayet davasında gerginlik yaşa…
13 Şubat 2018 17:55
Kayseri'de 15 askerin şehit olduğu terör saldırısı davasına deva…
13 Şubat 2018 17:55
Donmak üzere olan 4 kişi son anda kurtarıldı
13 Şubat 2018 17:55
Vali Karaloğlu'ndan turizmcilere fiyat uyarısı
13 Şubat 2018 17:55
Edirne'de kaçakların botu alabora oldu: 3 ölü, 7 kayıp (4)- Yeni…
13 Şubat 2018 17:55
Denizli Emniyet Müdürü: ByLock şüphelisi yakalamada yüzde 99 baş…
13 Şubat 2018 17:55
KRİPTOPARA - Sanal para birimlerinde toparlanma bekleniyor
13 Şubat 2018 17:55
Diş hekimine tehdit ve yumruklu saldırı iddiası
13 Şubat 2018 17:55 resimsizDenizlispor yönetimi suç duyurusunda bulunacak
13 Şubat 2018 17:55
Ak Parti kadın kollarında değişim
13 Şubat 2018 17:55
Kazada yaralanan genç kurtarılamadı
13 Şubat 2018 17:55
Assange'ın ''yakalama emri'' itirazı reddedildi
13 Şubat 2018 17:49
Nesnelerin İnterneti, kurumsal süreçleri nasıl etkiliyor?
13 Şubat 2018 17:49
Saldırıya uğrayan kripto para borsasına kullanıcılar dava açacak
13 Şubat 2018 17:49
Google, mobil arama sonuçlarında 'AMP Hikayeleri' özelliğini den…
13 Şubat 2018 16:48
Sınırın sıfır noktasında askerî hareketlilik
13 Şubat 2018 14:56
Umut veren araştırma: Yeni bir antibiyotik familyası keşfedildi
13 Şubat 2018 14:49
Rus mühendisler nükleer tesisin süper bilgisayarı ile bitcoin ma…
13 Şubat 2018 14:47
Nvidia’nın merakla beklenen GTX 2080 modeli geliyor
13 Şubat 2018 14:47
Boston Dynamics’in robotu kapıyı açıyor, arkadaşı için onu tutuy…
13 Şubat 2018 09:50
Turkcell ve Samsung 5G için güçlerini birleştiriyor
13 Şubat 2018 13:47
İYİ Partili Dervişoğlu: Tüm seçimlere girmeye hak kazandık
13 Şubat 2018 13:01 resimsizKızlarım İçin 11. bölüm fragmanı: Hüma'nın durumu Yaşar'ı üzecek!
13 Şubat 2018 13:01 resimsizFaruk Eczacıbaşı'dan 'Daha Yeni Başlıyor'
13 Şubat 2018 13:01
O şehit annesi: 2.5 lira için beni azarladılar (2)
13 Şubat 2018 13:01
Bahçeli: İlker Başbuğ'a sormak lazımdır, siyaset beka mücadelesi…
13 Şubat 2018 13:01 resimsizVagner Love Konyaspor'u boş geçmiyor
13 Şubat 2018 13:01
Hrant Dink davasında 2 tahliye
13 Şubat 2018 13:01 resimsizKış Olimpiyatları'nda sporcuların yüzlerine taktıkları bantların…
13 Şubat 2018 13:01
'Venezia Sahne' perdelerini çocuk oyunlarıyla açıyor
13 Şubat 2018 13:01
AKMEK'ten iş garantili kurs
13 Şubat 2018 13:01
Cumhurbaşkanı Erdoğan : Ömürlerinde hiç Osmanlı tokadı yememiş o…
13 Şubat 2018 13:01
Soner Göksay Karaca Kültür Merkezi'nde
13 Şubat 2018 13:01
Ortaca'da turizm toplantısı yapıldı
13 Şubat 2018 13:01HOTTEST NEWS IN TEHNOLOJI»
WHAT'S NEW IN TEHNOLOJI»
- Instagram'da mesajları 'görüldü' yapmadan ok…
- NASA, Ay programına 93 milyar dolar harcayac…
- 'Yemeksepeti hack'lendi 50 milyon kullanıcın…
- Internet Explorer, kullanıcıların başına bel…
- Windows'ta ekran kartı sıcaklığını öğrenmeni…
- Rusya havaya uçurdu! ABD ve NASA ayağa kalkt…
- Son teknoloji! Mehmetçik, teröristleri yerli…
- Twitter, zincir gönderileri birleştiren Thre…
- NVIDIA'nın 40 milyar dolara ARM'yi satın alm…
- Tunceli'de teröristlerin kullandığı 2 sığına…
- Ali Atay ve oğlu Fikret Ali'nin neşeli halle…
- Bakan Dönmez: Maden ihracatımız 4,38 milyar …
- WhatsApp'ta yeni dolandırıcılık yöntemi: Yak…
- Dünyanın en büyük elmas madeninde heyecanlan…
- Doğumda yeni bir ıkınma tekniği buldular
- Battlefield 2042 sistem gereksinimleri, çıkı…
- Tesla, Starlink internetini şarj istasyonlar…
- Siber saldırganlar, 2022 FIFA Dünya Kupası'n…
- Google'ın katlanabilir telefonu Google Pixel…
- Askerin güven kalkanı milli teknoloji! Sınır…


